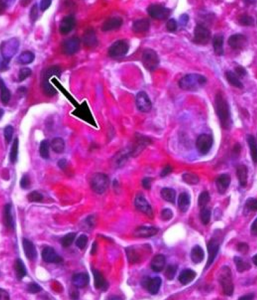
玻璃樣變性

介紹
 玻璃樣變性
玻璃樣變性
玻璃樣變性(hyaline degeneration),又稱透明變性,系指在細胞內或間質中,出現均質、半透明的玻璃樣物質,在HE染色切片中呈均質性紅染。它可以發生在結締組織、血管壁,有時也可見於細胞內。
玻璃樣變性
玻璃樣變性嬰兒型全身性玻璃樣變性是一種遺傳病,其會導致出生時或後有關節攣縮,紅色素於骨頭突出處大量形成,在真皮層內有玻璃樣透明物質聚集,並帶有全身性玻璃樣纖維瘤。...
病因學 臨床表現 遺傳模式 預後血管壁玻璃樣變性指的是由血管壁變薄引起的透明樣變性,常發生於脾、心、腎等器官的動脈管壁。
介紹 相關條目纖維結締組織玻璃樣變性常見於纖維瘢痕組織內。肉眼:灰白、半透明狀,質地堅韌,缺乏彈性。光鏡下:纖維細胞明顯變少,陳舊的膠原纖維增粗並互醫|學教育網蒐集整...
介紹 相關條目根據損傷輕重程度不同,分為可復性損傷和不可復性損傷兩大類,變性一般為可復性損傷,而細胞死亡則為不可復性損傷。變性(degeneration)系指細胞或間...
名詞解釋 生物變性 蛋白質的變性 面臨問題卵黃樣黃斑變性又稱Best病,是一種少見的常規染色體顯性遺傳性原發性黃斑部變性,屬黃斑部營養不良性疾病。卵黃樣黃斑變性發病隱匿且進展緩慢,患者容易忽視,...
概述 病因 臨床表現 檢查 診斷及鑑別診斷變性是物體的性質發生改變,物質屬性的自然(主動)或非自然(被動)改變。廣義上包括化學、生物甚至人類的性別。
名詞解釋 生物變性 蛋白質的變性 面臨問題主要表現為視網膜色素上皮細胞對視細胞外節盤膜吞噬消化能力下降,結果使未被完全消化的盤膜殘餘小體瀦留於基底部細胞原漿中,並向細胞外排出,沉積於Bruch膜...
介紹 病症類型 病因 發病機制 危害原發性視網膜色素變性是一種比較常見的毯層-視網膜變性。原發性視網膜色素變性(primary pigmentary degeneratio of the ...
概述 病因學 臨床表現 治療措施 併發症